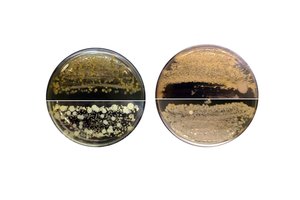
Pirmasis Lietuvoje išmaniųjų higienos tyrimas nustebino: bakterijų ant telefono daugiau nei lifte

„Neskiepyti žmonės yra potencialūs koronaviruso variantų fabrikai“, – CNN sakė Vanderbilto universiteto (JAV) Medicinos centro Užkrečiamųjų ligų skyriaus profesorius dr. Williamas Schaffneris.
„Kuo daugiau neskiepytų žmonių, tuo daugiau galimybių virusui daugintis“, – pridūrė jis.
Nauji viruso variantai išsivysto koronavirusu užsikrėtusio žmogaus organizme. „Kai tai įvyksta, virusas mutuoja ir gali sukurti dar pavojingesnį variantą“, – sakė dr. W.Schaffneris.
Virusai – įskaitant koronavirusą, sukeliantį COVID-19 – patiria mutacijas, ir nors kai kurios mutacijos gali net pakenkti pačiam virusui, kitos gali būti naudingos. Pavyzdžiui, mutacija gali paversti virusą lengviau perduodamu.
Kai virusas persiduos kitam asmeniui, mutacija replikuosis (dauginsis) ir plis, o jei pavyks – taps nauju koronaviruso variantu.
EK pirmininkė: mes susirūpinę dėl Delta atmainos, bet geroji žinia – vakcinos nuo jos apsaugo
„Atsiradus virusų mutacijoms, išlieka tos, kurios palengvina viruso plitimą populiacijoje“, – CNN sakė mikrobiologas ir imunologas Andrew Pekoszas iš Johnso HHopkinso Bloombergo Viešosios sveikatos mokyklos.
„Kiekvieną kartą, kai virusas keičiasi, tai virusui suteikia kitokią platformą, kuri gali pridėti daugiau mutacijų. Dabar turime virusų, kurie plinta daug efektyviau“, – sakė jis.
Bet jei virusas negali plisti, jis negali mutuoti.
Jau yra keli koronaviruso variantai, įskaitant keturis Pasaulio sveikatos organizacijos vadinamus „susirūpinimą keliančius variantus“.
Tai – „Alfa“, pirmą kartą atrastas Jungtinėje Karalystėje, „Beta“, pirmą kartą atrastas Pietų Afrikoje, „Gamma“, pirmą kartą atrastas Brazilijoje, ir „Delta“, pirmą kartą atrastas Indijoje. Visi šie variantai kelia padidintą riziką, nes arba pasižymi geresniu perduodamumu, arba sukelia sunkesnę ligos formą, arba gali išvengti imuninės apsaugos.
Šie variantai taip pat buvo atrasti tuo metu, kai susirgimų koronavirusu buvo itin daug.
Viešosios sveikatos ekspertai yra ypač susirūpinę dėl „Delta“ varianto keliamos rizikos net ir tiems, kurie jau pasiskiepijo. Nors nustatyta, kad vakcinos prieš naujus variantus yra pakankamai veiksmingos, kai kuriems skiepų efektyvumo vis dėlto gali nepakakti. Nustatyta, kad, pavyzdžiui, dvi „Pfizer“ vakcinos dozės yra tik 88 proc. veiksmingos užkertant kelią simptominiams „Delta“ varianto sukeltiems COVID-19 atvejams.
Tačiau JAV ekspertai nerimauja dėl to, kad šis variantas gali išplisti ir sukelti proveržių, ypač bendruomenėse, kuriose bendrasis skiepijimosi lygis yra žemas. Kuo mažiau vakcinuotų žmonių, tuo didesnė tikimybė, kad virusas peršoks iš vieno žmogaus į kitą.
„Šiuo metu maždaug 1 000 JAV apskričių skiepijimasis yra mažesnis nei 30 procentų. Šios bendruomenės, visų pirma Pietryčiuose ir Vidurio Vakaruose, yra labiausiai pažeidžiamos. Kai kuriose iš šių sričių jau pastebime augantį susirgimų skaičių“, – ketvirtadienį Baltuosiuose rūmuose surengtoje spaudos konferencijoje teigė JAV Ligų kontrolės ir prevencijos centrų direktorė dr. Rochelle Walensky.
Susiję straipsniai
„Kadangi „Delta“ variantas ir toliau plinta visoje šalyje, tikėtina, kad šiose bendruomenėse bus padidėjęs viruso perdavimas, nebent pasiskiepys daugiau žmonių“, – sakė ji.
Ekspertai ragina žmones intensyviau skiepytis – kad sustabdytų viruso plitimą.
Parengta pagal „Business Insider“.